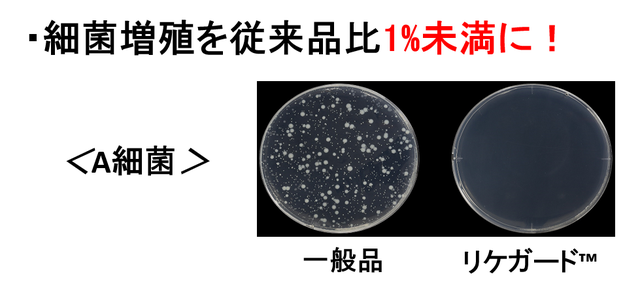

プロジェクト実行者
ストーリー
- 高透明×反射防止(AR)機能で着けていないかのような外観
- 新たな装着方法による、美しいフォルムとストレスフリーの両立
- リケガードフイルムで瞬時に特定のウイルスの数を減少させる(10年持続)


ものづくりの力でまだ終息の見えづらい感染症に対して何かできないか、その一心でHIRAX AIR SHIELDを開発しました。
抗ウイルス・抗菌SIAA認証マークを取得した高透明フィルムである「リケガード」を使用し、安心・安全に配慮しました。
さらに創業34年「メガネ21」とフェイスシールドを耳元で固定する仕組みを共同開発し、快適さを追求しました。
基本性能はもちろん、顔がきれいに見えるスマートなフォルムをご体感ください。


フィルムの選定でこだわっているのは安全・安心だけではありません。
充実したコミュニケーションの瞬間を演出し、かつ手元を見やすくするために
フィルムには 高い透明性と、反射防止機能が求められます。

そこで、リケガードフィルムの中でも、透明性・反射防止機能を兼ね備えた
ARフィルム(FS300)を使用し、より快適な視界を追求しました。

※自社販売予定の製品で比較しております。
また、特殊なコーティングによって高い耐久性を実現し、透明感が損なわれることなくご使用いただけます。




2020/05/07に、リケガードフィルムを使ったフェイスシールドを開発しました。
「安心して使える」「お手入れが簡単」「反射が少なくて使いやすい」など、使っていただいている方には概ね好評を頂いております。
一方で「見た目が悪い、ダサい。」「髪型や化粧が崩れる。」「暑い、洗いにくい。」など、フレームのデザインに関する課題が見えてきました。

この課題を解決するためには、「新しいデザインのフェイスシールド」を開発する必要があると考えました。そこで、HIRAXでは、ものづくりの力を結集して、ルックス・快適性・機能性を人間工学に基づいて追求。

フェイスシールドの最高峰にふさわしいこだわりを詰め込み、アップグレードしてクラウドファンディングに挑戦しました。


留め具は柔らかさと密着性のあるエラストマーを使用し、こめかみで固定します。
従来の製品のような額あてや鼻あてがないため軽く、ずれにくく、長時間使用してもストレスフリーです。

この革新的な装着方法は、メガネフィッターとして20年の経験を持つ
メガネ21取締役 平本氏監修のもとで開発しました。

「疲れない」「ズレない」「見た目が良い」デザインのノウハウ・技術を最も持っている業界はやはりメガネ業界です。
メガネ業界の中でも鼻あてを使わないで装着する【メガネ21】の「浮くメガネ」の技術を応用し、新しい形を実現しました。(特許出願中)

また、フレームには装着時の締め付け感を抑えつつ、安定感も両立させるために専用の強くしなやかな樹脂素材を使用しております。

「軽く、優しく、ズレにくい」をテーマに、ほどよいホールド感を保ちつつ、かぶれなど肌の弱い人にも配慮した素材を吟味しました。
もちろん、ルックスに関しても妥協のない設計を目指しております。

「いかに着けてない感じを演出できるか。」 に重点を置き
髪型やメイクを邪魔することなく、顔を美しく魅せるフォルムに仕上げました。

フレームに固定されたフィルムは、上下に動かすことができます。
汗を拭く時やドリンクを飲む時など、大変便利です。
フィルムを下まで降ろすと、フィルムと顔の距離がより近く、顎下約2㎝程度までカバーできます。このため、首を動かしてもフィルムが肩にあたることはありません。
また、顔を美しく魅せ、かつ邪魔しないよう、フィルムのトリミングにもこだわりを持って製作しております。

なめらかでスマートな、美しいルックスに徹底的にこだわりました。

フェイスシールドは飛沫が顔にかかるのを防ぐ重要な役割があり、今やフェイスシールドはマスクと同様に必要不可欠な飛沫防止ツールと言えます。
一度使用したフェイスシールドは飛沫が付着しており、フィルムをうっかり手で触るとフェイスシールドから手にウイルスがつく恐れがあります。

そこで、我々は 瞬時に特定のウイルスの数を減少させる抗ウイルスSIAA認証取得【リケガードフィルム】を採用しました。
リケガードフィルムは表面、裏面ともにを抗ウイルスコーティングを施しており、内側だけでなく外側からの飛沫もガードし、ウイルスが手につきにくくなります。
ラジカル反応により瞬時に特定のウイルスの数を減少させるため、アルコールや次亜塩素酸でのお手入れは不要です。
このフィルムは通常のフィルムの10倍以上の価格ですが、常に清潔な状態で使っていただくことは価格に代えがたい最重要項目であると考え妥協のない選定をしました。
※年間(365日)の使用回数で考えると1回あたりの金額は16.4円となっています。

大人から子供まで、すべての方に対応できるサイズ展開です( L / M / S )。

通常サイズ(L):顔幅140~170mm、顔縦幅160~200mm

小さめサイズ(M):顔幅110~140mm、顔縦幅140~180mm

子供サイズ(S):顔幅110~140mm、顔縦幅120~160mm

フレームは クリア と スモークブラック の2色からお選びいただけます。
クリア

スモークブラック

顔幅の測定方法

右こめかみ~左こめかみ までの間を測定してください。
顔縦幅の測定方法

額の中心からあご先までの距離を測定してください。

【飲食・アミューズメントなどの接客業】

【飲食、接客を伴うシーンに】 協力:RA様

【百貨店やアパレル業界】

【医療・介護・美容・エステなどの業界】
【歯科医の施術風景 】 協力:竹腰歯科医院様

【人の集まるイベント】
【ボイストレーニング・音楽教室】 協力:アクターズスクール広島校様

【普段使い】
【エンターテイメント】

【オフィスや打合せ】

どんな時でも優しく自然に。 AIRのある生活をお楽しみください。





お手入れは非常に簡単です。
アルコールや次亜塩素酸水による消毒を必要としません。
柔らかい素材の布で、軽くふき取っていただくだけで十分です。

1ヵ月新品交換保証
保証期間は購入日から1ヵ月です。
※お買い上げ日が不明の場合や購入時のレシート及び納品書紛失の場合、保証期間内であっても保証サービス対象外となります。
※正常に使用した場合のみ。
フレーム保証
製品品質上の問題で劣化や不具合が生じた場合、無料交換又は無料修理いたします。
ウイング保証
商品の品質に問題が生じた場合、無償交換又は無償修理をいたします。
国産高品質保証
完全日本製をお約束します。

早期に支援を確定いただいた方向けの【早期購入割】、複数枚購入向けの【大量購入割】を用意しました。
2020年9/1以降の発送を予定しております。

集めた資金は、全額を入金いただいた皆様へのフェイスシールド提供と、開発費に充てさせていただきます。

HIRAX

私たちHIRAXは平岡工業㈱で培った80年にわたるものづくりの経験を活かし
豊かな社会に貢献することを基本理念としています。
世界中の人々に必要とされ、笑顔をお届けする。今までのものづくりのカタチに捉われず、必要なものを必要な時に。ジャンルの枠組みを超え、新たな価値を創造する。
時に時計、時にテーブル、遊び心のある高品質な商品で笑顔あふれる生活をお届けする企業でありたい。様々なジャンルのプロフェッショナルとコラボレーションし、ものづくりの可能性を追求し続け、日本のものづくりを更なる高みへ昇華させ世界を驚かせる。
それが我々の想いです。

リスク&チャレンジ
使用感などに関しては、感じ方に個人差が予想されます。 使用感等に関する返品・返金はお受けいたしかねます。 ※製品不良以外に関する返品・返金はお受けいたしかねます。 ※仕様が一部変更になる可能性がございます。 ※環境によって、画像と実物とが異なって見える場合がございます。 ※ご支援の数が想定を上回った場合、製造工程上の都合等により出荷時期が遅れる場合がございます。 プロジェクトの性質上、以上の注意点につきましてあらかじめご理解とご了承いただいた上でご支援くださいますよう、よろしくお願い申し上げます。
サポーターからの応援コメント
文章のトップに戻る
応援購入する
このプロジェクトは現在、Makuakeストアにて販売中です。
【早割30%OFF】 HIRAX FACE SHIELD × 1個

5,600円(税込)
・完成した製品1個
〔一般販売予定価格 5,980円(税抜)の30%OFF〕
送料は1,000円です。
※フレームの色はクリア、スモークブラックの2種類から選べます。
シールドのサイズは通常、小さめ、子供用の3種類から選べます。
※皆様の応援購入により量産効率が向上した場合、正規販売価格が販売予定価格より下がる可能性もございます。
※デザイン・仕様は変更になる可能性もございます。ご了承ください。
※ご注文状況、使用部材の供給状況、製造工程上の都合等により出荷時期が遅れる場合があります。
【早割20%OFF】 HIRAX FACE SHIELD×1個

6,250円(税込)
・完成した製品1個
〔一般販売予定価格 5,980円(税抜)の20%OFF〕
送料は1,000円です。
※フレームの色はクリア、スモークブラックの2種類から選べます。
シールドのサイズは通常、小さめ、子供用の3種類から選べます。
※皆様の応援購入により量産効率が向上した場合、正規販売価格が販売予定価格より下がる可能性もございます。
※デザイン・仕様は変更になる可能性もございます。ご了承ください。
※ご注文状況、使用部材の供給状況、製造工程上の都合等により出荷時期が遅れる場合があります。
【大量購入割30%OFF】 HIRAX FACE SHIELD × 5個

24,000円(税込)
・完成した製品5個
〔一般販売予定価格 5,980円(税抜)×5個の30%OFF〕
送料は1,000円です。
※フレームの色はクリア、スモークブラックの2種類から選べます。
シールドのサイズは通常、小さめ、子供用の3種類から選べます。
※皆様の応援購入により量産効率が向上した場合、正規販売価格が販売予定価格より下がる可能性もございます。
※デザイン・仕様は変更になる可能性もございます。ご了承ください。
※ご注文状況、使用部材の供給状況、製造工程上の都合等により出荷時期が遅れる場合があります。
【大量購入割35%OFF】 HIRAX FACE SHIELD × 10個

44,000円(税込)
・完成した製品10個
〔一般販売予定価格 5,980円(税抜)×10個の35%OFF〕
送料は1,300円です。
※フレームの色はクリア、スモークブラックの2種類から選べます。
シールドのサイズは通常、小さめ、子供用の3種類から選べます。
※皆様の応援購入により量産効率が向上した場合、正規販売価格が販売予定価格より下がる可能性もございます。
※デザイン・仕様は変更になる可能性もございます。ご了承ください。
※ご注文状況、使用部材の供給状況、製造工程上の都合等により出荷時期が遅れる場合があります。
【大量購入割40%OFF】 HIRAX FACE SHIELD × 30個

120,000円(税込)
・完成した製品30個
〔一般販売予定価格 5,980円(税抜)×30個の40%OFF〕
送料は1,600円です。
※フレームの色はクリア、スモークブラックの2種類から選べます。
シールドのサイズは通常、小さめ、子供用の3種類から選べます。
※皆様の応援購入により量産効率が向上した場合、正規販売価格が販売予定価格より下がる可能性もございます。
※デザイン・仕様は変更になる可能性もございます。ご了承ください。
※ご注文状況、使用部材の供給状況、製造工程上の都合等により出荷時期が遅れる場合があります。
【超早割39%OFF】 HIRAX FACE SHIELD × 1個

5,000円(税込)
・完成した製品1個
〔一般販売予定価格 5,980円(税抜)の39%OFF〕
送料は1,000円です。
※フレームの色はクリア、スモークブラックの2種類から選べます。
シールドのサイズは通常、小さめ、子供用の3種類から選べます。
※皆様の応援購入により量産効率が向上した場合、正規販売価格が販売予定価格より下がる可能性もございます。
※デザイン・仕様は変更になる可能性もございます。ご了承ください。
※ご注文状況、使用部材の供給状況、製造工程上の都合等により出荷時期が遅れる場合があります。
「Makuake(マクアケ)」は、実行者の想いを応援購入によって実現するアタラシイものやサービスのプラットフォームです。このページは、 社会貢献カテゴリの 「【次世代フェイスシールド!】医療従事者や接客業も絶賛の抗ウイルス・高機能」プロジェクト詳細ページです。








